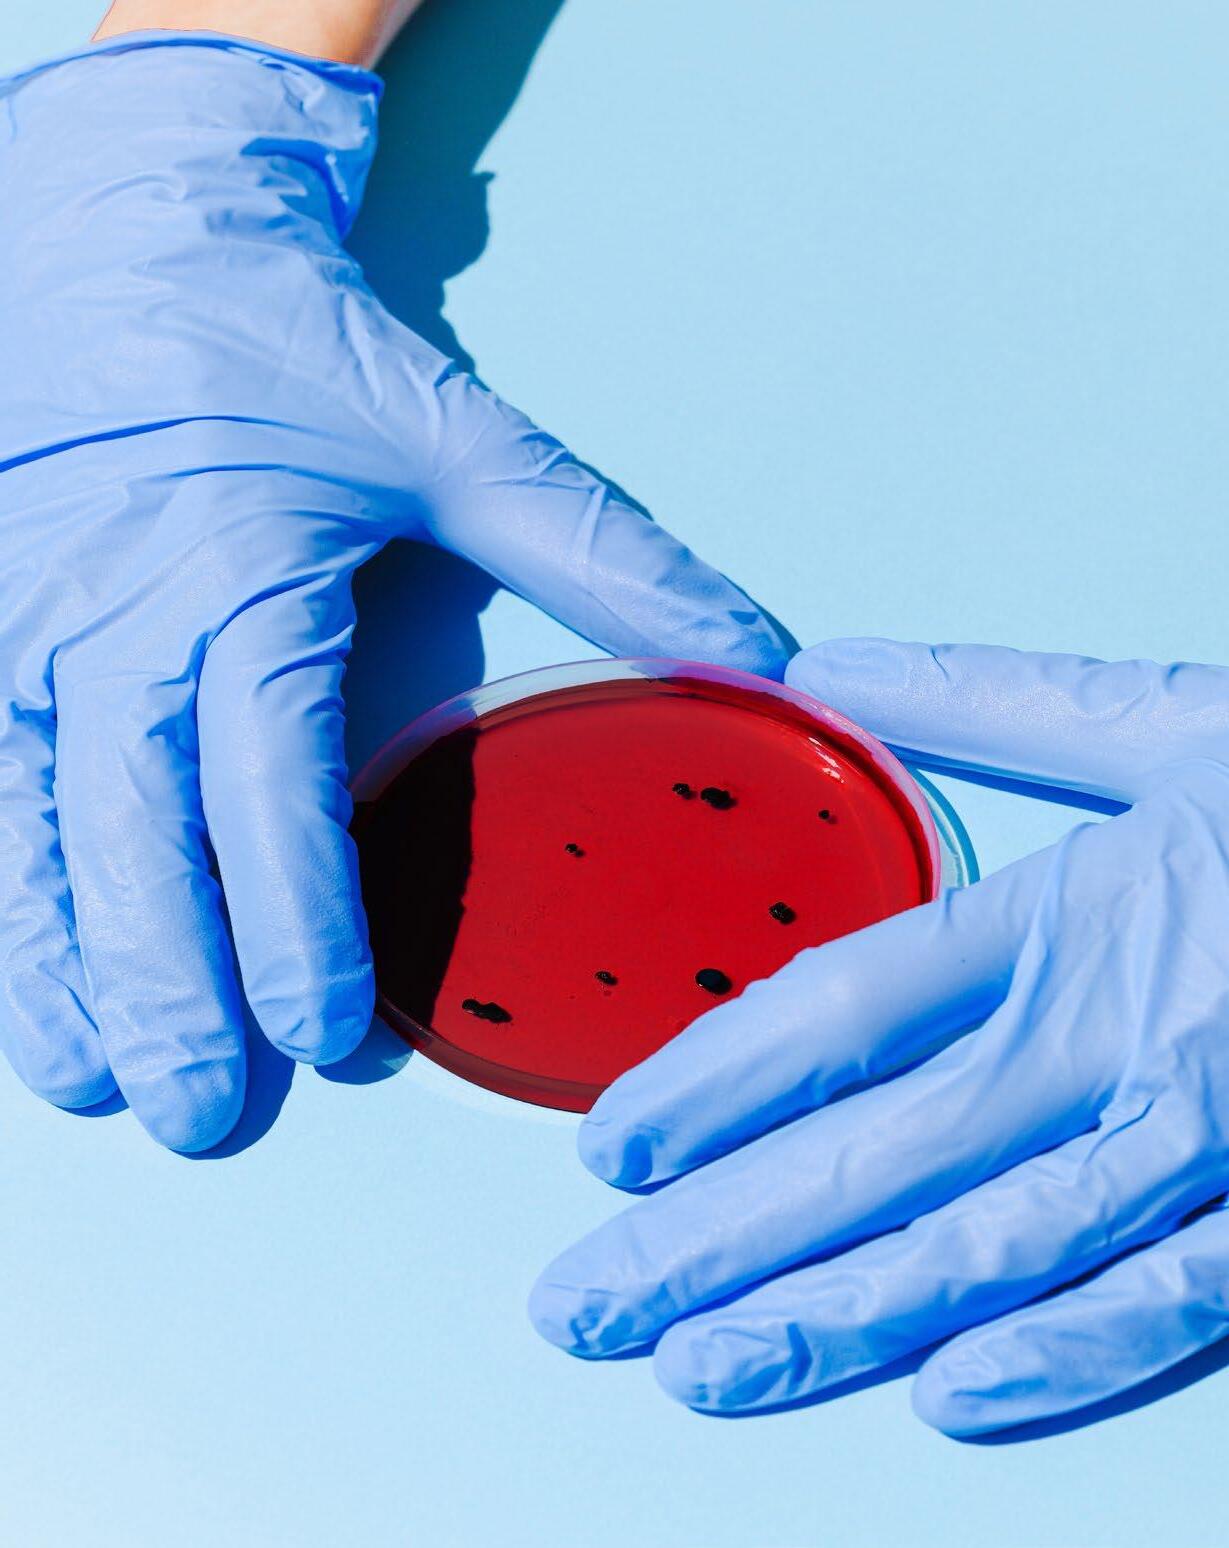

INNOVATIVE
FOR INTRODUCING AND PROVIDING COVERAGE FOR CELL & GENE THERAPIES A SIPC PUBLIC A TION SIPCONL I NE.N E T MAY 2023
STRATEGIES
Get the peace of mind and support it takes to self-fund your healthcare.
Self-insuring your healthcare benefits can open up new possibilities for your business — affording you greater flexibility in how you manage your healthcare spend. Trust the expert team at QBE to tailor a solution that meets your unique needs.

We offer a range of products for protecting your team and assets:
• Medical Stop Loss
• Captive Medical Stop Loss
• Organ Transplant
• Special Risk Accident
We’ll find the right answers together, so no matter what happens next, you can stay focused on your future.
To learn more, visit us at qbe.com/us/ah
QBE and the links logo are registered service marks of QBE Insurance Group Limited. ©2023 QBE Holdings, Inc. This literature is descriptive only. Actual coverage is subject to the terms, conditions, limitations and exclusions of the policy as issued. Crop Specialty Commercial
We’ll focus on risk, so you can take care of your business
Accident & Health Insurance
By Laura Carabello

 By Bruce Shutan
By Bruce Shutan
PUBLISHING DIRECTOR Erica Massey, SENIOR EDITOR Gretchen Grote, CONTRIBUTING EDITORS Mike Ferguson and Ryan Work, DIRECTOR OF ADVERTISING Shane Byars, EDITORIAL ADVISOR Bruce Shutan, 2023 Self-Insurers’ Publishing Corp. Officers James A. Kinder, CEO/Chairman, Erica M. Massey, President, Lynne Bolduc, Esq. Secretary

The Self-Insurer (ISSN 10913815) is published monthly by Self-Insurers’ Publishing Corp. (SIPC). Postmaster: Send address changes to The Self-Insurer Editorial and Advertising Office, P.O. Box 1237, Simpsonville, SC 29681,(888) 394-5688
TABLE
CONTENTS WWW.SIPCONLINE.NET MAY 2023 3
OF
MAY 2023 VOL 175
FEATURES
4 INNOVATIVE STRATEGIES FOR INTRODUCING AND PROVIDING COVERAGE FOR CELL & GENE THERAPIES
BETTER OUTCOMES
ENDEAVORS
16 HOLISTIC HEALTH HOLISTIC CARE THAT TREATS ROOT CAUSE OF DISEASE, RATHER THAN SYMPTOMS, HOLDS PROMISE FOR HELPING SELF-INSURED PLANS MAKE
THEIR ULTIMATE DESTINATION ARTICLES 60 NEWS FROM SIIA MEMBERS 34 ACA, HIPAA AND FEDERAL HEALTH BENEFIT MANDATES THE AFFORDABLE CARE ACT (ACA), THE HEALTH INSURANCE PORTABILITY AND ACCOUNTABILITY ACT OF 1996 (HIPAA) AND OTHER FEDERAL HEALTH BENEFIT MANDATES 44 SIIA
26 SMALL EMPLOYERS TURN TO CAPTIVES TO MANAGE RISING DRUG CLAIM COSTS
INNOVATIVE STRATEGIES FOR INTRODUCING AND PROVIDING COVERAGE FOR CELL & GENE THERAPIES

F
Written By Laura Carabello
For the first time, self-insured group health plan sponsors and leading manufacturers of cell and gene therapies (CGT) will come together during a SIIA-hosted Forum, May 31 – June 1, 2023, that is solely dedicated to discussing the introduction, cost and coverage options for these potentially lifesaving drugs.
Many ask the question: what are these therapies and what makes them different from drugs that are already in the market? Demonstrating that the therapies are providing a lifelong cure and not just another type of ongoing treatment will be key to justifying the pricing and gaining acceptance from patients, providers and employers/payers.
FEATURE
4 THE SELF-INSURER
Gene therapy does not treat symptoms – rather it targets the cause, the genetic defect behind a disease. Faulty genetic code may be replaced by inserting a gene that’s missing. Sometimes this can occur in a petri dish and the healthy cells are transferred to the patient. Alternatively, a vector, usually a virus, delivers the genetic material to the patient’s cells.
Treatment is currently restricted to those diseases caused by a single gene mutation and primarily target conditions that are typically rare, with patient populations in the hundreds or low thousands. But the landscape is rapidly changing and therapies for more common conditions, like sickle cell disease, are expected to arrive.
At the upcoming meeting, attendees will benefit from in-depth explanations.
As background, here are some brief definitions:
Cellular therapy (CT) is the transplantation of human cells to replace or repair damaged tissue and/or cells. With new technologies, innovative products, and limitless imagination, many different types of cells may be used as part of a therapy or treatment for a variety of diseases and conditions. Some of the cells that may be used include
hematopoietic (blood-forming) stem cells (HSC), skeletal muscle stem cells, mesenchymal stem cells, lymphocytes, dendritic cells, and pancreatic islet cells.
Source: Association for the Advancement of Blood & Biotherapies
GENE THERAPY
Gene therapy seeks to modify or manipulate the expression of a gene or to alter the biological properties of living cells for therapeutic use. Gene therapy is a technique that modifies a person’s genes to treat or cure disease. Gene therapies can work by several mechanisms:

MAY 2023 5
Cell & Gene Therapies Coverage
Complete, customizable TPA solutions
From locally-focused to national-scale programs, AmeriHealth Administrators offers a full spectrum of third-party administration and business process outsourcing services. Our scalable capabilities service many unique customers, including self-funded employers, Tribal nations, international travelers, and labor organizations.
We offer innovative solutions, insight, and expertise to help you manage your health plan and capabilities, control costs, and support employees’ health.
Visit amerihealth.com/tpa to learn more about how we can work with you.

• Replacing a disease-causing gene with a healthy copy of the gene
• Inactivating a disease-causing gene that is not functioning properly

• Introducing a new or modified gene into the body to help treat a disease
Gene therapy products are being studied to treat diseases including cancer, genetic diseases, and infectious diseases. Gene therapy products are biological products regulated by the FDA’s Center for Biologics Evaluation and Research (CBER). Clinical studies in humans require the submission of an investigational new drug application (IND) prior to initiating clinical studies in the United States. Marketing a gene therapy product requires submission and approval of a biologics license application (BLA).
Source: US Food and Drug Administration
Here’s the flip-side of stickershock over the cost of therapies: some call CGTs a relative bargain since they have, in some cases, the potential to cure illness with a single dose. Many regard this as a reprieve from the physical, emotional and financial burdens of living with a serious disease that often requires ongoing and highly expensive treatments.
MAY 2023 7
Cell & Gene Therapies Coverage
SPOTLIGHT ON CANCER
The Business Group on Health named cancer as the top driver of employer healthcare costs, a spot previously held by musculoskeletal conditions. In fact, 13% of employers surveyed say they have seen more late-stage cancers impacting their workforce, and 44% predict they will see an increase in cancer diagnoses in the future.
cells a new ‘set of instructions’ that can help them find and fight cancer. This is called genetic engineering, such as CAR T cells.
Researchers point to medication as the biggest expense associated with cancer care and that costs for breast, lung, lymphoma and colorectal cancers incurred the most expenditures. For example, Zynteglo, a gene therapy for a genetic blood disorder, debuted at $2.8 million.

CGTs harness the power of a patient’s own immune system to destroy cancer cells without harming healthy tissue. They work by changing the DNA within an individual’s existing cells to give those
In laymen terms, CAR T-cell therapies genetically engineer DNA in an individual’s T cells (which are part of that person’s immune system) using chimeric antigen receptors (CARs). This enables the T cells -- a natural and essential part of a person’s immune system -- to detect and destroy cancer cells. Today, the first-ever FDA-approved CAR T-cell treatments for blood cancers are saving lives.
8 THE SELF-INSURER
Cell & Gene Therapies Coverage
Skyrocketing prices. Administrative challenges. Shock claims. Aging workforces. At Amwins Group Benefits, we’re here to answer the call. We provide solutions to help your clients manage costs and take care of their people. So whether you need a partner for the day-to-day or a problem solver for the complex, our goal is simple: whenever you think of group benefits, you think of us.
We help you win.
The benefits landscape is broad and complex.
amwins.com
Different kinds of cancers have different kinds of biomarkers, which means different kinds of CGTs are required to fight them. They are personalized to attack specific cancer cells for specific patients.
Source: Alliance for Cancer Gene Therapy
SPOTLIGHT ON HEMOPHILIA
According to the CDC, hemophilia is usually an inherited bleeding disorder in which the blood does not clot properly. This can lead to spontaneous bleeding as well as bleeding following injuries

or surgery. Blood contains many proteins called clotting factors that can help to stop bleeding.
People with hemophilia have low levels of either factor VIII (8) or factor IX (9). The severity of hemophilia that a person has is determined by the amount of factor in the blood. The lower the amount of the factor, the more likely it is that bleeding will occur which can lead to serious health problems.

In rare cases, a person can develop hemophilia later in life. The majority of cases involve middle-aged or elderly people, or young women who have recently given birth or are in the later stages of pregnancy. This condition often resolves with appropriate treatment.
Hemgenix, a gene therapy that was launched at a cost of $3.5 million for a one-time infusion, treats adults with hemophilia B, a genetic bleeding disorder in which people do not produce a protein needed to create blood clots.

10 THE SELF-INSURER
product information,
ts.com Amalgamated Life Insurance Company Medical Stop Loss Insurance— The Essential, Excess Insurance Amalgamated Family of Companies Amalgamated Life ▲ Amalgamated Employee Benefits Administrators ▲ Amalgamated Medical Care Management ▲ Amalgamated Agency ▲ AliGraphics Group • Stop Loss • Voluntary Amalgamated Life Insurance Company 333 Westchester Avenue, White Plains, NY 10604 914.367.5000 • 866.975.4089 www.amalgamatedbenefits.com
For
contact: marketing@amalgamatedbene
VOLUNTARY SOLUTIONS—KEEPING PACE WITH TODAY’S NEEDS • Accident • AD&D • Critical Illness • ID Theft • Dental • Disability • Hearing • Whole Life Insurance • Specialty Rx Savings Programs and Discounts • “A” (Excellent) Rating from A.M. Best Company for 47 Consecutive Years • Licensed in all 50 States and the District of Columbia • Flexible Contract Terms • Legal • Portable Term Life • Excellent Claims Management Performance • Specific and Aggregate Stop Loss Options • Participating, Rate Cap and NNL Contract Terms Available Policy Form ALSLP-2020* *Features & form numbers may vary by state. A M BEST S A E len F nancia S rength Rating
As a direct writer of Stop Loss Insurance, we have the Expertise, Resources and Contract Flexibility to meet your Organization’s Stop Loss needs. Amalgamated Life offers:
Cell & Gene Therapies Coverage
“You have become a key partner in our company’s attempt to fix what’s broken in our healthcare system.”
- CFO, Commercial Construction Company
“Our clients have grown accustomed to Berkley’s high level of customer service.”
- Broker
“The most significant advancement regarding true cost containment we’ve seen in years.”
- President, Group Captive Member Company
“EmCap has allowed us to take far more control of our health insurance costs than can be done in the fully insured market.”
- President, Group Captive Member Company
“With EmCap, our company has been able to control pricing volatility that we would have faced with traditional Stop Loss.”
- HR Executive, Group Captive Member Company
People are talking about Medical Stop Loss Group Captive solutions from Berkley Accident and Health.
Our innovative EmCap® program can help employers with self-funded employee health plans to enjoy greater transparency, control, and stability.

Let’s discuss how we can help your clients reach their goals.
This example is illustrative only and not indicative of actual past or future results. Stop Loss is underwritten by Berkley Life and Health Insurance Company, a member company of W. R. Berkley Corporation and rated A+ (Superior) by A.M. Best, and involves the formation of a group captive insurance program that involves other employers and requires other legal entities. Berkley and its affiliates do not provide tax, legal, or regulatory advice concerning EmCap. You should seek appropriate tax, legal, regulatory, or other counsel regarding the EmCap program, including, but not limited to, counsel in the areas of ERISA, multiple employer welfare arrangements (MEWAs), taxation, and captives. EmCap is not available to all employers or in all states.
Stop Loss | Group Captives | Managed Care | Specialty Accident ©2022 Berkley Accident and Health, Hamilton Square, NJ 08690. All rights reserved. BAH AD2017-09 2/22 www.BerkleyAH.com
About 1 in 40,000 people have the disease, most of whom are men. Typical treatment requires routine intravenous infusions to maintain sufficient levels of the missing or deficient clotting factor, but the new gene therapy is meant to be a one-time IV infusion.
This new treatment option for patients with Hemophilia B represents important progress in the development of innovative therapies for those experiencing a high burden of disease associated with this form of hemophilia. In a recent cost-effectiveness analysis of the drug, weighing health benefits against offset costs, the Institute for Clinical and Economic Review (ICER) suggested that a fair price for the drug to be between $2.93 million and $2.96 million.
But the pushback to the high cost of current therapies for hemophilia is already underway. As pharmacy benefit managers (PBMs) increasingly exclude drugs from their formularies, advocates for patients with hemophilia are concerned about the drugs for bleeding disorders that BlueCross BlueShield of Tennessee (BCBST) has dropped from its 2023 formulary.

Also, be on the lookout for Roctavian for hemophilia A which may be approved by the FDA in July 2023 and is likely to be priced to cost between $2 million and $3 million per treatment.
MANAGING HIGH COSTS OF GENE THERAPIES
It should be noted that while gene therapies have the potential to treat or even cure life-limiting diseases, these advancements come at an enormous price tag of $850,000 to $3+ million per patient. When Hemgenix for the treatment of adults with Hemophilia B hit the market in November 2022, CNN reported that Hemgenix became the world’s most expensive drug at a $3.5 million price tag.
With FDA approval and commercial launch of novel CGT therapies, a bevy of these treatments for rare disease and complex conditions are now on the market. Ushering in a new era of medical care, these superexpensive drugs are challenging the acumen of even the most experienced benefits decisionmakers and risk strategists.
This is largely
12 THE SELF-INSURER
Cell & Gene Therapies Coverage On average, aequum r esolves c laims within 297 days of p lacement aequum has generated a savings of 95.5% off disputed c harges f or self-funded pl ans aequum ha s ha ndled claims in all 50 states 297 95.5% 50 No Guarantee of Results – Outcomes depend upon many factors and no attorney can guarantee a particular outcome or similar positive result in any particular case. Protecting
the
1111 Su perior A venue E ast Suite 1360 Cleveland, OH 44114 P 2 16-539-9370 www.aequumhealth. com
because products of this magnitude and cost have never before been available, leaving brokers, advisors, TPAs, stop-loss carriers or other service providers thirsting for information and credible guidance that they can offer to their employer-clients.
plans and patients across
U.S.
As background, here is a snapshot of past and projected launches:
Attendees at the upcoming meeting will not be disappointed in the scope and depth of data, material content and evidence that will presented by some of the most credible sources in the industry.
SIIA Cell + Gene Therapy Forum
May 31 – June 1
JW Marriott Minneapolis Mall of America
Minneapolis, MN
LEARNING OBJECTIVES
Source: McKinsey and Company. https://www.mckinsey.com/ industries/life-sciences/our-insights/eight-imperatives-for-launchingcell-and-gene-therapies

As of this writing, as many as 13 brand new cell or gene therapies could be approved for use in the US, Europe or both by the end of 2023. This puts us within reach of the FDA’s well-publicized 2019 prediction that it would approve 10-20 new cell and gene therapies a year by 2025. Please review the chart below:

Working with Liz Midtlien, Chairwoman, SIIA Board of Directors, Dr. Surya Singh, chief medical officer, Emerging Therapy Solutions, oversees the program development and chairs the opening panel which presents the manufacturers’ perspectives.

Providing an overview of the event, he says, “As the first event of its kind, manufacturers will engage with this audience and
Source: American Society of Cell and Gene Therapy www.ASCGT.org
MAY 2023 13 Cell & Gene Therapies Coverage
share their knowledge of the CGT pipeline, manufacturer viewpoints on pricing and outcomes, valuebased pricing and payment considerations, potential financial mitigation/risk strategies, plan document guidance and more. Panelists will cover key areas of interest that span pending product approvals, patient access considerations and development updates for rare diseases.”
Singh explains the four program pillars:
I. CLINICAL FOCUS
Attendees will benefit from a scientific discussion of CGTs and an insider look at the costs of administrating gene therapies – with both types being studied to treat medical conditions like certain types of cancer as well as genetic and inherited disorders.
• Ex-vivo which involves the genetic modification of cells outside of the body to produce therapeutic factors and their subsequent transplantation back into patients. Various cell types can be genetically engineered.
• In-vivo which uses viruses or other methods to deliver genes directly into the body’s cells.
II. PRODUCT PIPELINE UPDATES
2023 is expected to be a pivotal year for the introduction of new gene therapies, marked by the commercialization of Hemophilia A, sickle cell drugs and others as noted in the chart above. The anticipated approval and launch of additional therapies opens up opportunities for much larger populations, with expanded access through hospitals and outpatient facilities. In fact, 50% of hemophilia treatment centers are free-standing and independent of US health systems while the other half are affiliated with a major health system.
III. OPTIONS FOR RISK TRANSFER
Employers need to be resilient as they face the economic headwinds for coverage of CGTs. Amid the struggle to fit these therapies into the traditional benefit design for treatment and reimbursement of drugs to treat chronic diseases, they are prompted to collaborate with manufacturers and others that are developing multiple access pathways. These options for risk transfer are designed to help enable therapies to reach patients.

14 THE SELF-INSURER
Gene Therapies Coverage
Source: Emerging Therapy Solutions
Cell &
IV. FINANCIAL SOLUTIONS
Manufacturers are increasingly turning to innovative payment models that address employer/payer uncertainty across both financial (through discounts, price volume agreements, sales caps, annuities, etc.) and clinical outcomes (through outcomes-based agreements, coverage with evidence development, etc.). Many types of innovative agreements are now being presented and there are several options for manufacturers and employers to fulfill short- and long-term strategic access priorities and meet their distinct needs and expectations.
REGISTER NOW FOR THIS BLOCK-BUSTER EVENT

The self-insured community may never have this opportunity again in 2023 to learn how to offer CGTs and cost-effectively bring these potentially lifesaving therapies to employees. Plan documents will require re-structuring with new language that spells out changes. Making coverage determinations that account for risk will also be a concern as Health Plan Sponsors finalize underwriting decisions both from stop-loss and reinsurance perspectives.
Attendees will have an opportunity to ask questions, get answers and interact with speakers and participants. This is one event the self-insured community cannot afford to miss.
Visit www.siia.org to access program information and registration.
Laura Carabello holds a degree in Journalism from the Newhouse School of Communications at Syracuse University, is a recognized expert in medical travel, and is a widely published writer on healthcare issues. She is a Principal at CPR Strategic Marketing Communications. www.cpronline.com
MAY 2023 15 Cell & Gene Therapies Coverage
Written By Bruce Shutan

Holistic Health

HOLISTIC CARE THAT TREATS ROOT CAUSE OF DISEASE, RATHER THAN SYMPTOMS, HOLDS PROMISE FOR HELPING SELF-INSURED PLANS MAKE BETTER OUTCOMES THEIR ULTIMATE DESTINATION
WWith obesity and a host of chronic conditions affecting a growing number of Americans, the U.S. healthcare has been fixated on treating symptoms. The end result is costly pharmaceuticals and surgeries that are rendering care unaffordable for health plan participants and driving up the biggest P&L and negotiable expense for employers other than payroll in most organizations.
What’s missing from this equation is not only a lack of preventive medicine and holistic care from primary care physicians, but also health plan designs that address the root cause of health care problems.
16 THE SELF-INSURER
FEATURE
Examples include chiropractic care, acupuncture and naturopathic medicine that serve as an underground railroad of sorts for a reactive system that devotes far too many resources to health maintenance vs. preventing or even reversing costly problems.
These elements are part of a trend toward whole-person health whose focus is on “the interplay of multiple biological-psychological-social dimensions of health, with the goal of providing holistic, personalized and equitable support to employees on their well-being journey,” according to the National Alliance for Healthcare Purchaser Coalitions.
Self-insured plan sponsors are looking to ensure their various offerings are integrated and tailored to the participants’ needs and preferences, notes K. Andrew Crighton, M.D., chief medical officer for WellRight. “This means solutions are moving from a one-size-fits-all to more flexible delivery that can match one’s background, culture, race, gender and beliefs to providers and options that will encourage engagement.”
Two uphill battles involve a culture that’s resistant to meaningful lifestyle changes and fact that these outlying disciplines involve patient-centered interventions that vary with an individual’s needs and circumstances. In stark contrast, insurance-based care is more standardized, less variable and more predictable.

Treating root causes is by definition more variable and time consuming, according to Jennifer Gamboa, chief operating officer of Rehab Essentials, Inc., managing partner of Sustainable Health

Index and CEO and founder of Body Dynamics Inc. “Behavior change takes time,” she says.
However, that’s not to suggest mainstream Western medicine cannot participate in a more holistic model. Many healthcare disciplines are starting to recognize the importance of anticipatory care.
She notes that the American College of Lifestyle Medicine and Institute of Functional Medicine, two invaluable resources for self-insured health plans, train providers to view health care in a holistic way.
physical therapists, chiropractors, nutrition specialists and other health care providers.
MAY 2023 17
“Western medicine and U.S. health care is very much a reactive model,”
explains Bob Leonard, co-founder and board member of Spark Health, which blends naturopathic medicine with evidence-based methods featuring a team of medical and naturopathic doctors,
Andrew Crighton
Holistic Health
Bob Leonard
But semantics may be holding back on the potential for revolutionary change. Lorene Barulich, program manager, clinical process and training for

Nova Healthcare Administrators, prefers to describe a more proactive approach as “complimentary” instead of “alternative” medicine that skeptics may believe is not scientifically proven or snake oil.
COACHING PATIENTS TO SUCCESS
Whatever nomenclature is used, the fact is that employers have a great deal of influence over helping curtail poor habits, Crighton observes. He believes the key is explaining health risks to health plan members and coaching them to better health rather than dictating on what they need to do through a heavyhanded approach. “Just lay out the facts and let them decide for themselves,” he suggests.
Another important point he makes is to understand that everyone will have a different motivation for becoming healthier.
For example, it could be living long enough to walk one’s daughter down the aisle or see a grandson graduate. While making available financial incentives to adopt healthy behaviors may provide short-term gains, Crighton says it’s not a long-term solution or as powerful as each person’s unique motivation. Health coaches, clinical dietitians and mental health professionals who are often embedded in integrative, functional or lifestyle medicine help patients find root-cause care between primary care visits and execute on a plan of action, says Brian Schroeder, founder and CEO of the Preventia Group, LLC as well as president of the National Wellness Institute.
he opines. The trick, he explains, is taking data that’s available through a broker, health plan or vendor like Springbuk or Benefitfocus and making it more actionable.

What’s missing from many health care technologies is a scalable way to build a relationship with experts who are trained to manage behavior and lifestyle-based change.
he says.
“And right now, the current infrastructure for this type of care is does not exist. Their behavioral science will tell you that in order to make a meaningful change with anybody, you need to touch person 16 times over the course of a year.”
18 THE SELF-INSURER
“I’m a big believer in health risk appraisals and understanding what people are doing right now that either puts them at risk or mitigates a lot of risks that they may have.”
“We don’t have enough of them in healthcare,”
“That’s kind of where the rubber meets the road,”
Lorene Barulich
Holistic Health
Brian Schroeder
Medical Stop Loss from Berkshire Hathaway Specialty Insurance comes with a professional claims team committed to doing the right thing for our customers – and doing it fast. Our customers know they will be reimbursed rapidly and accurately – with the certainty you would expect from our formidable balance sheet and trusted brand. That’s a policy you can rely on.
right. www.bhspecialty.com/msl
done
The information contained herein is for general informational purposes only and does not constitute an offer to sell or a solicitation of an offer to buy any product or service. Any description set forth herein does not include all policy terms, conditions and exclusions. Please refer to the actual policy for complete details of coverage and exclusions.
Reimbursement
SEEING IS BELIEVING
While better education is a start to convincing people not to overindulge their sweet tooth or curb other unhealthy patterns, the most powerful motivation is actually seeing the results on someone, notes Michael Gorton, founder and CEO of Recuro Health.
He references many talented longevity physicians across the U.S., citing a local doctor in Texas named Jeff Gladden whose goal is to make 100 the new 30. “Imagine you’re in your late 60s, and you run into somebody from your high school graduating class who looks like they’re still 30?” he says. “You’re going to say, ’well, I’ve got to start doing that,’ and be inspired to try it.”
More employers are now viewing total health holistically through the prism of physical, cognitive, emotional, social, spiritual and financial well-being, according to Crighton. While emotional and mental health have been top of mind, he says many employers are starting to address the social determinants of health that influence one’s health status.


In addition, he reports that several health system clients are not only assessing the risk of their own employee population from a holistic perspective, but also offering this approach to other employers and
attempting to influence their local communities in this way.
Sharing critical resources with employees can help raise their healthcare literacy. “I think trusted and validated sources are going to be very important to highlight to your employee population,” Crighton says,
20 THE SELF-INSURER
Holistic Health
Michael Gorton
Betenbough Homes, a faithbased organization in West Texas and client of Schroeder, is a prime example of a forwardthinking self-insured employer’s approach to holistic health. It all started when CEO and founder Rick Betenbough decided to study alternative treatments to chemotherapy in the face of a devastating stage-four pancreatic cancer diagnosis. His triumphant uphill battle was baked into the entire organization.
“They’re looking to reinvent healthcare from the ground up,” Schroeder says, hoping to spend 90% of all of health care dollars on wellness as part of an “assurance” plan vs. traditional insurance plan.
A tangential issue may be the role health equity’s is playing in expanding the reach of holistic health approaches. Similar to how the journey unfolded at Betenbough Homes, Leonard has received calls from executives who have benefited from the holistic side of medicine and want to figure out how to make it work for their employees. Fanning out across the workforce “makes business sense,” he adds.
Self-funded employers have an opportunity to choose what options best fit their group and budget, Barulich notes. She says some employer clients will offer biometric outreaches involving follow-ups on blood testing for cholesterol and glucose, as well as blood pressure checks.
The objective is to make health plan members aware of their numbers and suggest a primary care visit to discuss the results. Employees at one particular company that offered free lunches sought healthier options such as a salad bar. With a menu of fried, greasy fast and inexpensive foods, it was no wonder that high cholesterol, obesity and diabetes were a nagging problem.
In some cases where groups limited chiropractic care and saw a spike in pain medicine or request for additional physical therapy, the TPA would suggest extending those services. “The ROI isn’t always on the dollar value,” Barulich points out, citing a reduction in addictive narcotics. “Ideally, the ROI truly would be you’re not jumping to hip replacements and back surgeries because you were able to get in sooner.”
HARNESSING TECH AND DATA
When Gorton started Teladoc, his initial thought was getting to rootcause problems with curative solutions vs. simply treating symptoms. He bristles at the fact that 24 years ago many states considered his vision illegal and unethical.
MAY 2023 21
“because not only are you going to be assessing their own risk, you’re going to be educating them on the past. A lot of times, what they will do is take the information to their own doctor and have that discussion.”
“This group cares for their employees. They’re seen as a major leader in anything that they do when it comes to employee benefits. There are hundreds of groups looking at Betenbough right now and studying what it is that they’re doing.”
Holistic Health
he says.
And while telehealth has made access to care easier, Gorton says it still hasn’t exactly made patients healthier. The answer eventually will come from using technology and collecting more expansive data to identify potential health problems before they become severe, he adds. Take measuring blood pressure, for instance. It’s a static data point that could very well have fluctuated a week or month ago. “If a doctor had the ability to see what your blood pressure was as a function of time, it would be so much more meaningful,” he explains. An ability to track that measure over, say, 12 straight days between 7 a.m. and 3 p.m., or the past six months to a year and spot any trendlines on a table, chart or graphic could lead to better intervention.
Using a smart scale to record bone mass and body fat among other metrics – not just weight – could go a long way toward helping patients address their health more holistically. But Gorton laments that
Moving from point solutions to a single, integrated multicondition experience produced improvements in A1c, systolic blood pressure and weight, according to a recent peerreviewed study by his former company, Teladoc Health.
Innovative solutions built around you.
A health plan that sets you apart
Your employees are your greatest asset, with needs that are always changing. You need a health plan that’s flexible to evolve with those needs—without compromising service, coverage, or the bottom line.
At HPI, we’re helping employers across industries offer health plans that impress their employees and the CFO.
We welcome clients of any size, any location, with many unique needs. If your client has a challenge, we have a solution.
Helping our clients support their greatest asset—their employees
• A la carte services, full replacement, or custom plan designs
• Regional, high-performance, national, tiered, and custom-built networks
• Pharmacy benefit integration with all major national PBMs
• Ancillary benefit administration COBRA, HRA, HSA, FSA, STD, dental, vision
• Preferred A-rated reinsurance carrier relationships
• Reference Based Pricing options
• Full-service Concierge
• Healthcare navigation tools
• AchieveHealth® integrated population health management solution
• AchieveWell® workplace wellness and incentive programs
• Captive arrangements
We love what we do.
hpiTPA.com
22 THE SELF-INSURER
“Today, 70% of the population would rather do a telemedicine visit than go to the doctor’s office,”
“lots of data is sitting there going nowhere. If you could pull it into a medical record, you start seeing trends to preemptively catch things.”
Holistic Health

What’s also helpful is to encourage a full panel of blood tests when patients are feeling healthy rather than when something goes wrong and it becomes a costly mess, Leonard suggests. His firm’s naturopathic doctors routinely order such testing four times a year. While some may argue that seems excessive, he says

A third area that he cites involves musculoskeletal disorders for those who are engaged in labor-intensive physical work. To prevent these injuries, he suggests pre-employment testing to ensure that job candidates have the physical capability to perform certain tasks instead of simply relying on verbal references.
Mindful that every individual’s DNA makeup is unique, Leonard says advanced nutrigenomics uncovers how the body reacts to certain foods and leads to certain disease states. Perhaps not surprisingly, two of the most common conditions that are driving cost involve diabetes and cardiovascular disease.
An over-reliance on doctors at the expense of more patient empowerment may be an even bigger issue when analyzing the potential for a more holistic approach to improve outcomes and lower cost.
24 THE SELF-INSURER
“the human body is dynamic not static. It’s always trying to achieve homeostasis. As our needs change to achieve this, so does our nutritional requirements and resultant supplement routine.”
Holistic Health
Says Gorton:
Bruce Shutan is a Portland, Oregon-based freelance writer who has closely covered the employee benefits industry for more than 30 years.

MAY 2023 25
“The best medicine in the world today is not at the Mayo Clinic, Cleveland Clinic or at the best doctor on the planet. It’s in the human immune system. We fight off cancer every single day when we’re healthy. The question is how do we stay healthy?”
Holistic Health
SMALL EMPLOYERS TURN TO CAPTIVES TO MANAGE RISING DRUG CLAIM COSTS
Written By Caroline McDonald
WWith prescription drug prices expected to continue to climb in 2023, employers are planning ahead. Having become comfortable with the concept of captives, companies of all sizes are increasingly entering the captive market to control these expenses.

“Drug price inflation is a significant cost driver, along with an increase in specialty drug utilization,” said Shawn Lanter, vice president, captive business development at Berkley Accident and Health Group. “Expensive cell and gene therapies continue to gain traction in the market and will be a major factor going forward. The pipeline of high dollar approved drugs is expected to grow exponentially in the coming years,” he said.
Lanter observed that stop-loss captives are on the rise, with a higher than ever number of employers looking to self-fund.
26 THE SELF-INSURER
Robby Kerr, senior vice president at Tokio Marine noted that more stop-loss carriers, managing general underwriters, and program sponsors are entering this space. “In addition, group stop-loss captive programs are really coming into their own now, because they’re past the early adopter phase and we’re seeing proof of concept,” he said. One reason captives have become so popular is that they allow employers with as few as 25 to 50 employees to become self-funded. An added feature of a captive is cutting down volatility, Kerr said.
In their group captive, Minnich noted, there are about 1,500 employers. “They go up to 500 and as low as 25 employees, the average is 100-200,” he said.
Most of the captives in the stoploss space are group captives, he added, explaining that many of the property-casualty captives are single entity, because multiple lines of business can be included in in the captive.
CAPTIVES FOR DRUG CLAIMS
Minnich said that organizations are increasingly using captives for high-cost drug claims because they have become a preferred risk pool for employers.
The reason, he said, is that being part of a captive puts them together with others who are likeminded, and “willing to spend a little up-front to generate savings on the back end.”

“A 50 lives employer is going to be reticent to become self-funded, because what if they have a bad year and get hammered with a huge increase?” asked Tony Minnich, vice president, captives, at Tokio Marine HHC, stop-loss group.
“With a captive we can mitigate both of those risks. It helps employers to wade into the water of self-funding.”
MAY 2023 27
Captives can also help organizations that are trying to change the way their claims are placed, he said. In this case, “We’re out there, unbiased, looking for whatever we can find to lower the cost of claims. And high-cost medications are certainly one of the top segments we’re looking at,” Minnich said.
MANAGING STOP-LOSS
To effectively manage stop-loss, employers in group stop-loss captive programs need to have a self-funding plan in place, Lanter explained.
Many of these programs can lower the plan’s spend significantly, “to the point of keeping an individual claim loss below the group-specific stoploss deductible,” he said. “If you’re able to avoid stop-loss claims through risk management strategies like these, you’re creating the opportunity for underwriting profit for the members within the group captive program.”
Secondly, he added, group captive programs create another financial opportunity for members by taking on stop-loss risk that they otherwise could not take on.

Focused on Clients. Dedicated to Results. Our Complex Claim Consulting Practice is committed to making your business better. www.lockton.com We have a team of Clinicians and risk managers working to simplify your most complex claims In s u ran ce • R isk Manag e m e n t • S u re ty Ex p ert i s e 2100 Ross Ave. Suite 1200 W E L I V E SE RV I C E ! Dallas, TX 75201 • 214.969.6100 © 2021 Lockton Companies A rights eserved Medical Benefits Complex Claims Pharmacy Analytics Risk Management
“Being self-funded creates the opportunity to integrate risk management solutions on an à la carte basis,” he said. “There are several progressive and effective programs in the market now that are focused on managing specialty Rx claims.”
28 THE SELF-INSURER



PAYMENTS DONE RIGHT Saving our customers over $1B a year. An end-to-end solution tailored to your needs: Contact us to learn more. echohealthinc.com | 440.835.3511 CONNECTION to over 1M+ vendors COMPLIANCE across HIPAA, PCI, OFAC, and IRS 1099 reporting EFFICIENCY that streamlines and reconciles through one system EASE OF USE with quick deployment and training for your team
he said, adding that a key benefit with group stop-loss captives is the opportunity to alleviate laser exposure – which is assigning a higher deductible for an individual with a known condition
INDUSTRIES
Captives in the early days, especially on the P&C side, were much more industry specific, Minnich said. “Often it would be for workers’ compensation, so it made sense for concrete contractors to work together because they had, and understood, the same risks,” he said.
With health benefits, however, this is not the case, he added, as injuries related to a particular industry are covered by workers’ comp. “Ten years ago, we had a lot of industry-specific captives, now all our captives are heterogenous,” Minnich said.
And third, employers in group captive programs “can leverage their collective buying power to negotiate discounts with cost-containment vendors, such as specialty pharmacy benefits managers. As a group, they can negotiate lower pricing than they could individually,” Lanter said.

“If the captive risk pool can manage potential catastrophic claims, such as specialty Rx, they’re creating an additional level of financial efficiency and buying as little risk-transferred insurance as possible,” Lanter said. Group captives “can also leverage the overall captive risk pool to help mitigate the ongoing exposure of high-cost drug claimants,”
– “and the volatility that goes along with that.”
30 THE SELF-INSURER
TRENDS
The current trend is captives in general, as more and more companies are exploring and forming them, Kerr said. “It’s a tremendous way for people to buy insurance for their stoploss. It’s also easier for them to understand their insurance.”
Minnich noted that another trend he sees is additional ways to obtain data.“They call it artificial intelligence,” he said. “It isn’t Terminator II, but we’re finding better ways to use the intelligence we have to make informed decisions.”
While a company may not have a long claims history available, “We can see where they are,

what they do, and there are a lot of demographic factors we can look at,” Minnich said. That information can be used to make an informed decision “of where we think they will be. This helps smaller employers to be more comfortable moving into self-funding,” he said.
As a captive, organizations have data that can be used for their benefit. For example, “They know that 29 members are taking blood pressure medication and six of them didn’t fill their scrip that month,” Minnich said.
While the company can’t call these individuals out, and might not even know who they are, “They can hold a luncheon where they talk about how important it is to refill their medications,” he said. “The idea is to be aware of the issues that affect claims costs and then do something about it over time, because being in a stop-loss captive is not a 12-month deal – it is a five-to-10-year deal.”
Caroline McDonald is an award-winning journalist who has reported on a wide variety of insurance topics. Her beat has included in-depth coverage of risk management and captives.
Imagine the possibilities with Markel® and Nevaeh
Markel has developed a strategic collaboration with Nevaeh to provide new product solutions for employer accident and health coverage.
Nevaeh products have distinct advantages, but working together provides a leveraging effect that’s called the Nevaeh advantage which includes:

• Employer stop loss insurance
• Supplemental medical and accident insurance
• Outpatient, PBM carve-out plans
For more information, visit nevaehinsurance.com
Coverage is underwritten by Markel Insurance Company, NAIC # 38970, 10275 West Higgins Road, Suite 750, Rosemont, IL 60018. Terms and conditions for rate and coverage may vary by state and application. Insurance and coverage are subject to availability and qualifications and may not be available in all states. Markel® is a registered trademark of the Markel Corporation. Producer marketing materials. © 2022 Markel Service, Incorporated. All rights reserved. markel.com
MAY 2023 31
RISE OF DRUG COSTS
According to the Price Increases for Prescription Drugs report, 2016-2022 by the Assistant Secretary for Planning and Evaluation:
• In January 2022, the average price increase was nearly $150 per drug (10 percent), and in July 2022, it was $250 (7.8 percent). July increases tended to be for higher priced drugs than those in January, resulting in higher dollar increases but smaller percentage increases. Results in 2022 were affected in part by the high recent rate of general inflation. The Consumer Price Index for all Urban Consumers (CPI-U) increased by 8.5 percent between July 2021 and July 2022.

• In 2022, several drugs increased their list prices by more than $20,000 or by more than 500 percent.
• The Inflation Reduction Act introduced a new requirement for manufacturers to pay rebates to Medicare for Part D drugs whose price increases exceed inflation, beginning Oct. 1, 2022, which was designed to reduce the frequency and size of drug price increases.
There is much research and development involved in the process of creating new drugs, Minnich said, “However, we exist on a pretty thin profit margin in the stop-loss arena and some of the profit margins we see on drugs are pretty outrageous.”
One of the reasons captives are more effective overall, he said, is that they are a different model. “Standard insurance is the insurer versus the insured—the member versus the carrier,” Minnich explained. In a captive, however, “all three members of the equation are together, because they are all looking to keep overall costs low.”
32 THE SELF-INSURER

ACA, HIPAA AND FEDERAL HEALTH BENEFIT MANDATES:
PRACTICAL Q & A

Q & A
TheAffordable Care Act (ACA), the Health Insurance Portability and Accountability Act of 1996 (HIPAA) and other federal health benefit mandates (e.g., the Mental Health Parity Act, the Newborns and Mothers Health Protection Act, and the Women’s Health and Cancer Rights Act) dramatically impact the administration of self-insured health plans. This monthly column provides practical answers to administration questions and current guidance on ACA, HIPAA and other federal benefit mandates.
Attorneys John R. Hickman, Ashley Gillihan, Carolyn Smith, Ken Johnson, Amy Heppner, and Laurie Kirkwood provide the answers in this column. Mr. Hickman is partner in charge of the Health Benefits Practice with Alston & Bird, LLP, an Atlanta, New York, Los Angeles, Charlotte, Dallas and Washington, D.C. law firm. Ashley, Carolyn, Ken, Amy, and Laurie are senior members in the Health Benefits Practice. Answers are provided as general guidance on the subjects covered in the question and are not provided as legal advice to the questioner’s situation. Any legal issues should be reviewed by your legal counsel to apply the law to the particular facts of your situation. Readers are encouraged to send questions by E-MAIL to Mr. Hickman at john.hickman@alston.com.
34 THE SELF-INSURER
CAN I GET A WITNESS? PREPARING FOR GAG CLAUSE ATTESTATIONS
Beginning this year, group health plans are required to submit an annual gag clause compliance attestation to the Department of Health and Human Services (HHS), which is collecting the attestations on behalf of itself and the Departments of Labor and Treasury.
The attestation is required to confirm that certain contracts do not prevent disclosures of cost, quality of care data, or certain other information required as part of the Consolidated Appropriations Act of 2021 (CAA).
The Centers for Medicare and Medicaid Services (CMS) have posted several compliance resources on its website, including Annual Submission Webform Instructions (“Submission Instructions”) that provide an overview of the process; a User Manual for making attestations through the Health Insurance Oversight System (HIOS) that walks through the submission process step-by-step with screenshots from the webform; and FAQs About Affordable Care Act and Consolidated Appropriations Act, 2021 Implementation Part 57 (FAQs Part 57), which were issued by the departments on February 23, 2023.
The annual attestation requirement applies to most group health plans, including both self-insured and fully-insured ERISA plans, church plans, non-Federal governmental plans, and grandfathered plans.
Account-based plans, such as health reimbursement arrangements and health flexible spending accounts, or excepted benefit plans (e.g., hospital indemnity, dental, vision, long-term care) are not required to submit attestations.
The rule against gag clauses was part of the surprise medical billing transparency disclosures that require plans to disclose price and quality information to plan participants, as required by the CAA.
The attestation confirms that the plan has not, since December 27, 2020, entered into any agreement with a provider, network of providers, TPA, or any other service provider offering access to a network or association of providers that contains any prohibited gag clause. Attestations must be made through HIOS by December 31, 2023, and annually by December 31 thereafter.
Plans will need to take a number of steps to prepare for the attestation. In this article we look at the practical aspects of preparing ahead for submissions from both the self-insured plan side and TPA side.
Plan sponsors should consider preparing an inventory of their contracts and agreements and determine which ones require an attestation. Advanced coordination with TPAs and service providers will be needed to determine whether the plan or the TPA will submit the attestation.
The plan sponsor will need to identify and authorize an appropriate individual within the plan to make the attestation or authorize a TPA to do so on the plan’s behalf. TPAs should review the Submission Instructions and User Manual to gather all the relevant information for each entity on whose behalf they will be attesting.
Lastly, plans that have contracted with a service provider to attest on behalf of the plan will want to obtain proof that the attestation was submitted.
INVENTORY OF COVERED AGREEMENTS
Compiling an inventory of all current plan agreements/ renewals and amendments will help plan sponsors organize and document their attestation process. At a minimum, an inventory will tag the execution dates, effective dates, and subject matter (e.g., medical, pharmacy benefits, behavioral health) for each agreement (include renewals and amendments) and should include a review column indicating whether the agreement is free from prohibited gag clauses.
MAY 2023 35
The dates of the agreement are relevant for ensuring that the attestation covers only those agreements within the applicable reporting period. Tagging agreements by type is necessary if a plan sponsor will not be attesting on its own behalf for all of its agreements.
As discussed below in Who Submits?, TPAs and other service providers can attest on behalf of a plan for a subset of plan benefits (e.g., pharmacy benefits), so plans will need to have a methodology for tracking who is attesting for each type of agreement.
Which types of agreements/ contracts are subject to the requirement? The gag clause






sCL specialty pharmacy:
rules apply to agreements with providers, network of providers, TPA, or any other service provider offering access to a network or association of providers. Because account-based plans are exempt from these rules, agreements with, for example, a service provider that provides services only for administration of a health reimbursement arrangement or health flexible spending account would not need to be included in the inventory.
Does every agreement currently in effect need to be reviewed for gag clause compliance? The short answer is yes, at least for longterm compliance, although it may be that only a subset of current agreements fall within the initial period for gag clause attestation purposes. FAQs Part 57 Q6 states that the first attestation covers the period beginning December 27, 2020, or the effective date of the applicable group health plan (if later), through the date of attestation.


This language does not state whether amendments are needed for agreements entered into prior to December 27, 2020 and still in force on/after that date. The attestation language in the CMS User Manual is somewhat clearer, requiring attestation that the plan “will not enter into an agreement, and has not, subsequent to December 27, 2020, entered into an agreement” that contains a prohibited gag clause (emphasis added).

Alternative funding integration AUTOMATED Dispensing Pharmacy High-TouchSUPPORT HIGH-TECH SOLUTIONS Script Care’s Specialty Pharmacy Program offers a solution to effectively reduce specialty costs through automated processing and review technology; adaptable, advanced integration capabilities with alternative funding providers; and highly-trained clinical professionals dedicated to improving patient care. flexible specialty copay program INTERNAL SPECIALTY MANAGEMENT SCRIPT CARE FIND OUT HOW WE COULD TODAY! (800) 880-9988 // WWW.SCRIPTCARE.COM CUT YOUR SPECIALTY PROGRAM COSTS
36 THE SELF-INSURER
The implication here is that an amendment to remove a gag clause from an agreement entered into prior to December 27, 2020 is not required for making the attestation. So, for purposes of the attestation due by December 31, 2023, only agreements entered into or amended “subsequent to December 27, 2020” need to be reviewed.
PRACTICE POINTER: THE INVENTORY OF AGREEMENTS CAN BE USED BY PLAN SPONSORS TO MAKE NOTE OF THE NEED TO REMOVE THE GAG CLAUSE FROM EARLIER AGREEMENTS UPON RENEWAL OR AMENDMENT.
This raises another issue: amendment to the agreement. The current FAQs Part 57 do not address how to treat agreements that were entered into prior to December 27, 2020 but later amended, and whether this places the agreement within the current reporting period.
For example, if a service agreement that included a gag clause was entered into on January 1, 2020 (i.e., prior to December 27, 2020), and then amended January 1, 2021 for fee adjustments, does the postDecember 27, 2020 amendment place the entire agreement within the current reporting period?
What if the amendment were to a part of the agreement more closely associated with gag clauses, such as the confidentiality or privacy provisions? These questions are not answered in the FAQs Part 57, and additional guidance would be helpful.
What is a prohibited gag clause? Once the plan sponsor has identified which agreements require attestation, each agreement needs to be reviewed to ensure that it does not contain a gag clause. Plan sponsors attesting on their own behalf may want to engage legal counsel to assist with this process.
Generally, a prohibited gag clause is a direct or indirect restriction on sharing certain types of information with certain plan stakeholders (see the FAQs Part 57 for more detail).
The prohibition against gag clauses does not prevent the data owner from including reasonable restrictions on public disclosure of the information. Nor does it mandate that service providers freely provide this information to the plan sponsor or its business associates.
The review, for attestation purposes, is to ensure that the agreement includes no direct or indirect prohibition. When looking at an agreement entered into after December 27, 2020, the plan sponsor should, at a minimum, ask the following:
• Does this agreement contain language that restricts sharing provider specific cost or quality of care information with a plan stakeholder (i.e., other providers, eligible employees/
participants, and the plan sponsor) through a consumer engagement tool or with a business associate?
• Does this agreement restrict the plan’s or a business associate’s electronic access to deidentified claims and encounter information (financial information such as the allowed amount, provider name and clinical designation, service codes and any other data included in claims and encounter information)?
• If there are limits on that access, are they the result of privacy laws or are they intended to restrict public disclosure of the information?
With regard to privacy laws and restrictions on public disclosures, HIPAA (Health Insurance Portability and Accountability Act) limits disclosure of protected health information to the “minimum necessary” to satisfy the purpose or carry out a function.
And, of course, reasonable requirements to protect the data from breach and/or unauthorized access would be permissible. So even if the agreement contains some restrictions, the restrictions do not violate the prohibition against gag clauses if the restriction is in place due to HIPAA or other applicable privacy laws.
MAY 2023 37
IF YOU’VE BEEN HOARDING HIGHLIGHTERS


We know what it’s like to feel FOMA, or Fear Of Missing Anything. That’s why we invented Curv ®, so you can zero in on catastrophic claims risks with the industry’s most predictive and trusted risk score, making it easier than ever to see more stop loss risks and opportunities— and competitively price plans across your spectrum of underwritten groups.

PRACTICE POINTER: GOING FORWARD, PLAN SPONSORS MAY WANT TO NOT ONLY REVIEW NEW AGREEMENT FOR GAG CLAUSES, BUT ALSO INCLUDE AFFIRMATIVE LANGUAGE THAT CLARIFIES THEIR RIGHT TO DISCLOSE PROVIDER SPECIFIC COST/ QUALITY OF CARE THROUGH CONSUMER ENGAGEMENT TOOL OR OTHER MEANS, ACCESS CERTAIN DE-IDENTIFIED CLAIMS AND CLAIM ENCOUNTER INFORMATION, AND SHARE WITH BUSINESS ASSOCIATES AS PERMITTED BY PRIVACY LAWS.
Can a plan sponsor “cure” a prohibited gag clause by amendment? There is no guidance on whether an agreement with a prohibited gag clause entered into after December 27, 2020 can be “cured” for attestation purposes by an amendment to remove the gag clause prior to attestation.
Moreover, neither the User Manual nor the Submission Instructions allow for an attester to disclose an amendment to remove a gag clause to a postDecember 27, 2020 agreement. The attestation format is set up to allow attestations in the affirmative, with no opportunity to voluntarily disclose agreements that were “cured” by amendment. More guidance from the departments would be welcomed.
SUBMITTING THE ATTESTATION
Who submits the attestation? As explained in the Submission Instructions, the attester is the person who actually signs off on the attestation, and the “submitter” is the person who enters the data into the webform.
The submitter and attester can be the same person, but if they are not, each person will need to provide their contact information in the webform. Submitters will want to read the User Manual and Submission Instructions in advance in order to gather all the required data for the submission.
A self-insured plan can submit an attestation on its own behalf, or it can contract with service providers such as its third-party administrator (TPA) or pharmacy benefit manager (PBM) to submit an attestation on behalf of the plan.
Plan sponsors that submit on their own behalf will need to identify an appropriate individual within the plan to be the attester. Attesters are required to affirm that they are properly authorized as part of the attestation process.
The Submission Instructions explain that if the plan uses more than one TPA to administer various subsets of plan benefits, each TPA can attest on behalf of the subset of the plan that it administers.
The submission form includes three categories of agreements— medical, pharmacy, and behavioral health—along with a wild card column for “other types of provider agreements.” A plan could, for example, attest on its own behalf for medical and behavioral health, but contract with the PBM to attest on the plan’s behalf for pharmacy.
What is the process for accessing HIOS for purposes of the attestation submission? As explained in the FAQs Part 57 Q12 and Submission Instructions, an authentication code is required to access the HIOS webform where the attestation is completed and submitted.
The process seems straightforward: a code is generated by email within 10 minutes to any user who properly requests one. Codes are active for 15 days, and after the code expires, a new code must be obtained.
What time period does the plan’s attestation cover? The first attestation is due no later than December 31, 2023, covering the period beginning December 27, 2020 (or the effective date of the applicable group health plan, if later) through the date of attestation. Attestations covering the period since the last preceding attestation are due by December 31 of each year thereafter. Consequently, attestations for each plan will cover different time periods based the date of attestation.
MAY 2023 39




















What is the process for TPAs submitting on behalf of a plan? A plan can authorize a TPA or other service provider to be the official “attesting entity” and submit the attestation on behalf the entire plan or subset(s) of plan benefits. As part of the attestation submission process, the attester will be required to affirm that it has proper authorization from the plan (or applicable reporting entity).
Because this affirmation is made by the attester and not the plan sponsor, attesters will want to ensure that proper authorizations are in place prior to submitting the attestation.

If a TPA is acting as attester on behalf of multiple plans, information for each plan will be entered on a single template. This information includes (among other items) the Employer Identification Number, plan number used on Form 5500s, plan mailing address, and the name of the plan’s point-of-contact, as well as that person’s email address and phone number.
The TPA will need to properly identify the type of plan (i.e., ERISA plan, church plan, non-federal governmental plan, or health issuer) and the type of provider agreements that apply to the attestation (e.g., medical, PBM, behavioral health). See the explanation for “Option B” in the Submission Instructions for more details on TPAs submitting attestations on behalf of multiple plans.
ENFORCEMENT ACTION
Regardless of whether the plan or the TPA is tasked with submitting, the plan is ultimately responsible if there is a failure to submit an attestation on time.

The agencies state in FAQs Part 57 Q7 that failure to submit timely attestations may subject the plan to enforcement action, without specifying what type of action. Presumably the general penalty of $100 per day under the Internal Revenue Code could be applied, but it isn’t clear if this would apply per attestation, or per person affected by the violation.
The Submission Instructions explain that after the attestation is successfully submitted by the TPA, the submitter can download
STOP LOSS | CAPTIVE | PAYOR | PROVIDER | GROUP ACCIDENT At StarLine, our track record speaks for itself. It’s one built on trust and expertise. Our data-driven customized solutions offer clarity amidst complexities and reflect a forward-thinking, collaborative mindset. We pride ourselves on staying ahead of the curve with an eye to innovation and look to the future wtih confidence. starlinegroup.com | (508) 809-3179
MAY 2023 41
Bringing the Power of Consumerism to Healthcare
A first-of-its-kind healthcare SuperApp for self-funded plan sponsors that helps members make better decisions around quality medical care delivery, so everyone wins.


The only self-funded healthcare engagement platform of its kind.
Hercules Health rewards habitual app utilization by giving cash incentives earned through intelligent healthcare shopping tied to quality and cost. More app use equals more savings for members and plan sponsors alike.


Comprehensive Compliance
Hercules Health delivers best-in-class price transparency that is fully compliant with the Transparency in Coverage (TiC) and the No Surprises Act (NSA) rules and regulations.
Contact us today.
herculeshealth.com
info@herculeshealth.com
a confirmation receipt as a PDF file. Plans should contact any TPA or service provider that attested on the plan’s behalf and request a copy of this receipt.
SUMMARY CHECKLIST
In preparing for the attestation process, plan sponsors may find it helpful to:
• Compile an inventory of covered agreements

• Maintain a sub-list from the inventory of agreements entered into prior to December 27, 2020 that will subsequently need to be amended to remove prohibited gag clauses
• Identify an appropriate individual to make the attestation and ensure that proper authorizations are in place
• If contracting with a TPA to make the attestation, ensure that proper authorizations are in place
• Obtain proof of submission from TPAs attesting on behalf of the plan or any subset of plan benefits
MAY 2023 43
SIIA ENDEAVORS
SIIA HAS TWO IN-PERSON EVENTS COMING IN MAY

SIIA CORPORATE GROWTH FORUM
May 15-17, 2023
Westin Poinsett Hotel
Greenville, SC
SIIA’s Corporate Growth Forum is designed to help companies active in the self-insurance/captive insurance marketplace better understand growth strategies made possible by corporate financial transactions (mergers, acquisitions, capitalizations, etc.) and engage directly with selected equity groups.
ENDEAVORS
44 THE SELF-INSURER
The program will feature content useful to entrepreneurs and strategic planning executives interested in exploring private equity options and developing important relationships to further their business objectives. Valuable to companies ranging from start-ups to established corporate entities, everyone will come away with vital information and insights.
Attendees have the opportunity to present their organization to all Growth Partners as well as schedule private meetings directly with selected equity firms. To review a list of private equity firms that have confirmed their participation visit https://www.siiaconferences.org/ corporategrowth/2023/index.cfm
Networking and Program highlights include:
LET US INTRODUCE OURSELVES…
Attendees will have the opportunity to introduce their companies to the growth partner sponsors via private, five-minute presentations (one company/attendee at a time presenting to the full group of growth partner sponsors). Advance sign-ups will be required. Given the limited time available, requests will be accommodated on a first come basis.
Note: Only sponsoring companies will have access to these SIIA private member pitches.
WELCOME NETWORKING RECEPTION
SIIA FUTURE LEADERS
MEET-UP MIXER
SIIA Future Leaders (under 40) meet-up for an after-dinner networking event. Details to be announced closer to the date.
WELCOME REMARKS & PROGRAM OVERVIEW
SPEAKERS
Mike Ferguson
President & CEO
Self-Insurance Institute of America, Inc.

Orlo “Spike” Dietrich
Operating Partner
The Ansley Capital Group
SPEAKING THE LANGUAGE OF GROWTH
Corporate financial transactions are, even for seasoned business executives, a venture into a new and complicated world. Two specific areas often contribute to most of the confusion.
MAY 2023 45 ENDEAVORS




























Strong relationships. More solutions. Partner with Nationwide® to simplify Medical Stop Loss for you and your clients. Save time and e ort with easy access to experienced underwriters who o er a broad range of solutions. Our flexible plans are tailored to fit your clients’ needs and reduce future risk. Plus, claims are backed by a carrier with A+ financial ratings.* O er coverage from a brand clients can trust. Nationwide has been in the health business for 80 years and in Medical Stop Loss for nearly 20 years. To learn why top Medical Stop Loss producers and underwriters choose Nationwide, call 1-888-674-0385 or email stoploss@nationwide.com. *A+ ranking from AM Best received 10/17/02, a rmed 12/1/22, and A+ ranking from Standard & Poor’s received 12/22/08, a rmed 4/19/22. Plans are underwritten by Nationwide Life Insurance Company, Columbus, Ohio 43215. Nationwide, the Nationwide N and Eagle, and Nationwide is on your side are service marks of Nationwide Mutual Insurance Company. © 2023 Nationwide NSV-0113AO (01/23)
First, there are jargons, acronyms, and terminology that are not a part of our normal business conversation, and often have different interpretations, depending upon the sophistication of the user.

Secondly, understanding the optional “sources of capital” and the best fit for your company, requires both a clear understanding of what you are trying to accomplish, and which sources are better suited to help you achieve these goals.
With this in mind, the opening session provides an orientation to these topics, which will get you prepared for the rest of the educational program.
SPEAKERS
Mary Catherine Person
Consultant
Blue General Partners
CANARX sets the standard for safety and savings, making us the smart choice for self-funded health plans and their members, who get maintenance medications at zero copay.
John Vujovich
Vice President, Corporate Development

Point C
Brian Poger
Operating Partner
Frazier Healthcare Partners

CONTACT US TODAY FOR YOUR FREE SAVINGS ASSESSMENT canarx.com
1-888-739-2718 SIMPLE. SAFE. SMART. ENDEAVORS MAY 2023 47
|

Being Powerful. Being Human. Being PharmPix. Partnership is within your grasp. Discover why PharmPix has been revolutionizing PBM since 2009. Schedule a personalized demo at www.pharmpix.com or call 404-566-2000.
POWERED BY ONEARK
UNDERSTANDING HOW DEALS ACTUALLY COME TOGETHER
Before you make the decision to consider bringing in outside capital, securing a majority investor, or even selling your company, it is critical that you understand how your initial decisions will drive the ultimate success of this process, and the pitfalls to be avoided.
Many SIIA companies are approached by entities seeking an investment or acquisition opportunity, and understanding the process involved with “running a process” or doing a “targeted” transaction, and the probable outcomes (both financial and strategic) is critical.
achieve your goals.
SPEAKER
Sean Fogarty
Partner, Co-Chair of Corporate & Finance Practice

Arnall Golden Gregory LLP
Premier Broker Support.
REAL WORLD FINANCIAL TRANSACTIONS STORIES FROM SIIA MEMBERS


This session will feature a panel of SIIA members who have engaged in various transactions who will provide real-world perspectives on what went right, what went wrong, and what they wish they know prior to their transactions.
MODERATOR
Amanda Eisel- CEO
Zelis
SPEAKERS
Rob Gelb- CEO
Valenz® Health
Ben Frisch- CEO
Point C
Jeff Bakke- CEO
Health EZ
Bill Ashley
Executive Vice President
Allied National
Less of everything that holds you back. More of everything that makes you great. Scan to request a demo. ©2023 BenefitMall. All Rights Reserved.
Our speaker will walk us through how to understand these processes and how to choose the better one to
ENDEAVORS MAY 2023 49
In addition to claims and benefits administration, we offer pharmacy benefit management, health and wellness programs and stop-loss insurance, all backed by a dedicated in-house customer support team.
We simplify health benefits administration. Contact us today! 866.930.PCMI quotes@pinnacletpa.com www.pinnacletpa.com Pinnacle Claims Management understands the importance of providing affordable and comprehensive benefit solutions for employers, employees
their families. As a
third-party
for self-funded employers, we’re committed to maximizing your health plan savings with innovative, customizable and cost-saving solutions
your
and
leading
administrator
that will make the biggest impact for
employees.
MEETING TIME
The afternoon has been reserved for attendees to meet with growth partners and/or visit with other attendees. Our large session room will remain open and available for meetings.
WHAT INVESTORS REALLY WANT
Attendees will have the opportunity to hear from a panel of investors active in the selfinsurance marketplace on how they evaluate opportunities and approach and negotiate transaction structures.
The panel will also provide advice how to best attract the attention of potential financial partners including venture capital, private equity mezzanine (and other debt structures), and strategic investors.
SPEAKERS
Michael Burcham
Chief
of
Strategy & Talent
Development
Shore Capital Partners
Brett Carlson- CEO
Eir Partners
ALL ABOUT THE MULTIPLES
This session will take a deep dive on multiples (future cash flows), specifically for types of companies involved with self-insurance/ captive insurance.
Related valuation considerations such as earn-outs, stock options and true-ups will also be discussed.
In the final analysis, investors are buying some, or all, of your company’s future cash flow. The scale (size), stability and growth of these expected cash flows will drive the value an investor will place on a company. Multiples bring this value into context of where you are today.
SPEAKER
Trey Marinello
Managing Director
Houlihan Lokey
SHARE, ASK & ANSWER
We’ve reserved the last hour of the program for a moderated group discussion where attendees will be encouraged to share their transaction experiences, ask questions, and invite answers to those questions. This will be great opportunity to round out your educational experience.
MODERATOR
Mike Taylor Executive Partner
Council Capital CEO, Alivia Analytics
MEETING TIME
Richard Fleder
President & CEO
ELMC Risk Solutions, LLC
The afternoon has been reserved for attendees to meet with growth partners and/or visit with other attendees. Our large session room will remain open and available for meetings. There are many other smaller meeting areas withing the host hotel, as well as nearby venues.
ENDEAVORS MAY 2023 51

SIIA CELL AND GENE THERAPY STAKEHOLDER FORUM
May 31 - June 1, 2023
JW Marriott Mall of America
Minneapolis, MN
SIIA members consistently cite Cell & Gene Therapy (CGT) as one of the most important issues affecting the self-insurance industry, with this importance only expected to increase in the years ahead.
Responding to this feedback, SIIA is pleased to announce its inaugural Cell & Gene Therapy Stakeholder Forum. Join leading experts in the field as well as thought leaders from the selfinsurance industry who will discuss the ongoing and mounting risk of paying for these potentially life-saving, yet high-cost therapies.
You will leave with detailed knowledge of the CGT pipeline, manufacturer perspective on pricing, value-based pricing consideration, potential financial mitigation/risk strategies, plan document guidance and more.
Attendees will also have multiple opportunities to directly engage with each other, which promises to maximize the knowledge-sharing experience and to help facilitate business partnership opportunities.
Networking and Program highlights include:
CELL & GENE THERAPY - THE BASICS
Discussing cell & gene therapy can be complicated. Before addressing specific industry trends, implications and perspectives throughout the day, this session will cover CGT basics, including definitions and how treatments come to the marketplace.
SPEAKER:
Dr. Surya Singh
Chief
Medical Officer
Emerging Therapy Solutions
Do you aspire to be a published author?
We would like to invite you to share your insight and submit an article to The Self-Insurer! SIIA’s official magazine is distributed in a digital and print format to reach 10,000 readers all over the world.
The Self-Insurer has been delivering information to top-level executives in the self-insurance industry since 1984.
Articles or guideline inquires can be submitted to Editor Gretchen Grote at ggrote@ sipconline.net
The Self-Insurer also has advertising opportunties available. Please contact Shane Byars at sbyars@ sipconline.net for advertising information.

ENDEAVORS MAY 2023 53
Depend on Sun Life to help you manage risk and help your employees live healthier lives

By supporting people in the moments that matter, we can improve health outcomes and help employers manage costs.
For over 40 years, self-funded employers have trusted Sun Life to help them manage financial risk. But we know that behind every claim is a person facing a health challenge and we are ready to do more to help people navigate complicated healthcare decisions and achieve better health outcomes. Sun Life now offers care navigation and health advocacy services through Health Navigator, to help your employees and their families get the right care at the right time – and help you save money. Let us support you with innovative health and risk solutions for your business. It is time to rethink what you expect from your stop-loss partner.
Ask your Sun Life Stop-Loss Specialist about what is new at Sun Life.
The content on this page is not approved for use in New Mexico. For current financial ratings of underwriting companies by independent rating agencies, visit our corporate website at www.sunlife.com. For more information about Sun Life products, visit www.sunlife.com/us. Stop-Loss policies are underwritten by Sun Life Assurance Company of Canada (Wellesley Hills, MA) in all states except New York, under Policy Form Series 07-SL REV 7-12. In New York, Stop-Loss policies are underwritten by Sun Life and Health Insurance Company (U.S.) (Lansing, MI) under Policy Form Series 07-NYSL REV 7-12. Product offerings may not be available in all states and may vary depending on state laws and regulations. © 2023 Sun Life Assurance Company of Canada, Wellesley Hills, MA 02481. All rights reserved. Sun Life and the globe symbol are trademarks of Sun Life Assurance Company of Canada. Visit us at www.sunlife.com/us.
BRAD-6503-y SLPC 29427 01/22 (exp. 01/24)
THE MANUFACTURERS PERSPECTIVE
This panel discussion will feature some of the leading CGT manufacturers who will provide an overview of CGT treatments now available and those in the pipeline.
The panel will also address pricing implications existing as well as pending approvals, valuebased payments, patient access considerations and development updates for rare diseases.
MODERATOR:
Dr. Surya Singh
Chief Medical Officer
Emerging Therapy Solutions
SPEAKERS:
Tim Keyes
Senior Director US Value, Access & Pricing
Kite Pharma
Tim Holderman
National Gene Therapy Commercial Payer Lead

Spark Therapeutics
Robert Rouse
Head of Market Access
CSL Behring
MAY 2023 55
ENDEAVORS
PLAN DOCUMENT CONSIDERATIONS FOR CGT COVERAGE
As self-insured group health plan sponsors decide whether and how to cover CGT, it is critical that their plan documents are structured properly - don’t assume that standard plan document language accounts for CGT. A leading industry expert tells you what you need to know.
SPEAKER:
Jennifer McCormick
Vice President, Consulting
The Phia Group
THE PHYSICIAN AND PATIENT PERSPECTIVES
Physicians and patients obviously have important perspectives on the CGT that could be useful in helping plans make coverage decisions while also assisting their risk partners in making underwriting decisions. A sampling of those perspectives will be provided during this session.
SPEAKERS:
Dr. Paul Orchard
Medical Director of Inherited Metabolic Disease
Program & Professor of Pediatric BMT & Cellular Therapy
University of Minnesota
Get some tips during this session from those who have had successful talks with employers, as well as from an employer representative.
MODERATOR:
Ward Humphreys
Senior Vice President, National Healthcare Practice
Risk Strategies
SPEAKERS:
Cameron Deml
Vice President of Strategic Business Relationships
Brown & Brown
Jason Ellison
National Healthcare Practice –Employee Benefits
Risk Strategies
Erica Barnes
Executive Director
Minnesota Rare Disease Advisory Council
TALKING TO EMPLOYERS ABOUT CGT
Whether you are a broker/advisor, TPA, stop-loss carrier or other service provider, you may have to have “the talk” with your selfinsured employer clients about CGT coverage...do you know what to say?
Marty Laskowski
Vice President of Risk Management
Allied Benefit Solutions
PAYING THE CGT TAB
As costs continue to increase, risk takers are taking a closer look at long term solution strategies that will allow for ongoing CGT coverage - both
ENDEAVORS 56 THE SELF-INSURER

You Can. Discover The Value Of Partnership A Full Service MGU Program Manager Custom Plans | EPO | RBP | PPO | Level Funding What If You Could Have The Value Of A Direct Carrier, With The Underwriting Expertise Of An MGU?
ENDEAVORS
from a stop-loss and reinsurance perspective.
This session will feature an interactive panel discussionincluding audience participation - exploring how industry thoughtleaders are approaching this challenge.
MODERATOR:
Robby Kerr
Senior Vice President
Tokio Marine HCC
SPEAKERS:
Kristi Bohn
Vice President of Reinsurance
RGA
Jeremy Freestone
SVP, Medical Stop-Loss
Symetra Financial
Kelly Munger- Head of US Health Partner RE
Shaun Peterson
Head of Health Solutions Pricing
Voya
Tasha Barbour
Managing Director, Reinsurance Solutions
Aon
SHARE, ASK, ANSWER
By now we will have covered a lot of ground. This last hour has been reserved for a “freestyle” discussion where attendees can interact with the speakers and each other to share their experiences, ask questions and help answer questions from others.
MODERATOR:
Dave McClean
CEO
Emerging Therapy Solutions
For more information including registration and sponsorship opportunities for both events, visit www.siia.org.

58 THE SELF-INSURER
You want unparalleled customer service. Employers need the right stop loss coverage. At Swiss Re Corporate Solutions, we deliver both. We combine cutting-edge risk knowledge with tech-driven solutions and a commitment to put our customers first. We make it easy to do business with us and relentlessly go above and beyond to make stop loss simpler, smarter, faster and better. We’re addressing industry inefficiencies and customer pain points, moving the industry forward – rethinking employer stop loss coverage with you in mind. corporatesolutions.swissre.com/esl
Employer Stop Loss: Limit Health Care Exposure.

Insurance products underwritten by Swiss Re Corporate Solutions America Insurance Corporation. © Swiss Re 2022. All rights reserved.
Together.
Advancing Self-funding
NEWS FROM SIIA MEMBERS
2023 MAY MEMBER NEWS

SIIA Diamond, Gold, and Silver member companies are leaders in the self-insurance/captive insurance marketplace. Provided below are news highlights from these upgraded members. News items should be submitted to membernews@siia.org.
All submissions are subject to editing for brevity. Information about upgraded memberships can be accessed online at www.siia.org.
If you would like to learn more about the benefits of SIIA’s premium memberships, please contact Jennifer Ivy at jivy@siia.org.
NEWS 60 THE SELF-INSURER
DIAMOND MEMBERS
SUN LIFE US APPOINTS MILES VARN, MD, AS CHIEF MEDICAL OFFICER
WELLESLEY, Mass., -- Sun Life
U.S. announced that Miles Varn, M.D., has been named chief medical officer (CMO), a newly created position, as it expands further into the health space with benefits that help people access the care they need. Dr. Varn will play a critical role in the growth of clinical strategies for Sun Life’s U.S.’ clients, in order to improve health outcomes.
Dr. Varn is also head of PinnacleCare, the care navigation company Sun Life acquired in 2021, which provides personal care advisors to help people access the right diagnoses, doctors and treatments for their specific medical needs.
“Miles has dedicated his career as a practicing emergency medicine physician and at PinnacleCare to helping people get the best care possible, and I am pleased to appoint him as our chief medical officer for Sun Life U.S.,” said Dan Fishbein M.D., president of Sun Life U.S. “Our goal is to help people access the care and benefits they need. By enhancing the clinical focus of the benefits and services we offer, Sun Life will increasingly serve as a key connector in the healthcare ecosystem to help produce
better health outcomes. Miles’ expertise will guide our skilled team of healthcare professionals across our business as we continue to develop health-related services and solutions for our clients.”
As CMO, Dr. Varn will provide clinical leadership to the approximately 120 health professionals across Sun Life’s U.S. business. He will create a new clinical council designed to coordinate clinical approaches and best practices, and provide insight into products, policies, and initiatives to address the most pressing healthcare issues facing members.
About Sun Life U.S.
Sun Life U.S. is one of the largest providers of employee and government benefits, helping more than 50 million Americans access the healthcare and coverage they need. Through employers, industry partners and government programs, Sun Life offers a portfolio of benefits and services, including dental, vision, disability, absence management, life, supplemental health, medical stop-loss insurance, and healthcare navigation. Sun Life U.S. and affiliated companies in asset management employ approximately 8,000 people in the U.S. Group insurance policies are issued by Sun Life Assurance Company of Canada (Wellesley Hills, Mass.), except in New York, where policies are issued by Sun Life and Health Insurance Company (U.S.) (Lansing, Mich.). For more information visit our website and newsroom. Visit www.sunlife.com/us/en
GOLD MEMBERS
SL MANAGEMENT ANNOUNCES THE SUCCESSFUL TRANSITION OF AMERICAN FIDELITY ASSURANCE COMPANY’S DIRECT STOP LOSS DIVISION
SL Management Partners, LLC (SL Management) is pleased to announce the successful transition of American Fidelity Assurance Company’s (AFA) Direct Stop Loss division to their new Program Management company founded by Steve Solomon and Robert Lang.
Solomon and Lang originally contracted with AFA in 2017 to build a stop loss team and develop a successful underwriting, distribution, and service platform for the carrier. At the end of 2022, AFA made the corporate decision to exit the Medical Stop Loss Insurance product line and focus their resources on their core benefits business. SL Management has executed a Program Management Agreement with AFA to service their existing customer business and continue to write new and renewal business through June 2023.
NEWS MAY 2023 61
We Know... Risk
We study it, research it, speak on it, share insights on it and pioneer new ways to manage it. With underwriters who have many years of experience as well as deep specialty and technical expertise, we’re proud to be known as experts in understanding risk. We continually search for fresh approaches, respond proactively to market changes, and bring new flexibility to our products. Our clients have been benefiting from our expertise for over 45 years. To be prepared for what tomorrow brings, contact us for all your medical stop loss and organ transplant needs.

Visit us online at tmhcc.com/life Tokio Marine HCC - Stop Loss Group A member of the Tokio Marine HCC Group of Companies TMHCC1185 - 04/2023 HCC Life Insurance Company operating as Tokio Marine HCC - Stop Loss Group
Ron Byrne, President of the Strategic Alliances division of American Fidelity who oversaw the Direct Stop Loss division explains AFA’s decision. “We explored several options over the past twelve months with this Division and believe transitioning the business unit to Solomon, Lang and their team was the natural fit for the policyholders and business producers. Our brand is very important to us, and we know our customers will receive excellent service through this transition. The move allows AFA to focus more resources on their core benefits products and solutions.”
Steve Solomon added
Key to this announcement is their planned stop loss carrier partners moving forward. SL Management has reached agreement to represent two well-respected national stop loss carriers as a full-service Medical Stop Loss Program Manager.
The powerful new partnership provides both carriers with the opportunity to continue their rapid growth in the medical stop loss market. SL Management looks forward to introducing their current AFA policyholders and long-term production partners to their new stop loss carriers under separate press releases in conjunction with each carrier.
Bob Lang commented, “We couldn’t be more excited to introduce our customers to our new carrier partners and educate them on the benefits of trusting both carriers with their stop loss insurance needs. We have been incredibly impressed with their professionalism, capabilities, and industry knowledge. Highly rated stop loss carriers with strong financials and the desire to take risk are incredibly important in the current environment.”
The transition to SL Management Partners will be completed by April 1, 2023. We welcome all our customers to visit our website at www.StopLossPartners.com.
Contact info below:
Robert Lang, Managing Director
Bob.Lang@StopLossPartners.com
Office: (978) 623-4317
Cell: (781) 307-2530
Lori Sartori, VP of Sales & Marketing
Lori.Sartori@StopLossPartners. com
Office: (978) 623-4765
Cell: (612) 418-0266
Steve Solomon, Managing Director
Steve.Solomon@ StopLossPartners.com
Office: (978) 623-4802
Cell: (781) 307-1667
“We are happy to announce our entire stop loss team has joined us for this exciting opportunity! Our Management Team has spent decades developing successful value-added sales and risk management services for the self-funded community. The consultative and relationship focus we bring to our partners has always positioned us favorably in the stop loss market.”
NEWS MAY 2023 63
EARLY STARTS BUILD HEALTHY LIVES
Staying healthy depends on being proactive. So does spend management. At Vālenz® Health, we believe lowering healthcare costs is driven by the ability to engage early and often in the member’s healthcare journey.

Before a claim even begins, we use data to identify cost, network and plan design opportunities to drive cost containment and improved health outcomes for members. We ensure everyone is aligned. There are no surprises – just reduced costs, better outcomes, and an improved member experience from start to finish.
That’s our promise to you. This is precisely why our customers stay with Valenz, because no one else does what we do.
See how Valenz engages early and often to deliver smarter, better, faster healthcare: visit valenzhealth.com or call (866) 762-4455.
 Proud to be a Diamond Member
Proud to be a Diamond Member
SELF INSURANCE INSTITUTE OF AMERICA, INC. 2023
BOARD OF DIRECTORS
CHAIRWOMAN OF THE BOARD*
Elizabeth Midtlien
Vice President, Emerging Markets
AmeriHealth Administrators, Inc.
Bloomington, MN
CHAIRMAN ELECT & TREASURER AND CORPORATE SECRETARY *
John Capasso
President & CEO
Captive Planning Associates, LLC
Marlton, NJ
DIRECTOR
Stacy Borans
Founder/Chief Medical Officer
Advanced Medical Strategies
Lynnfield, MA
DIRECTOR
Matt Kirk President
The Benecon Group
Lititz, PA
DIRECTOR
Mark Combs
CEO/President
Self-Insured Reporting
Greenville, SC
DIRECTOR
Shaun L. Peterson
VP, Stop Loss
Voya Financial
Minneapolis, MN
DIRECTOR
Amy Gasbarro
Chief Operating Officer
Vālenz
Phoenix, AZ
DIRECTOR
Adam Russo CEO
The Phia Group, LLC
Canton, MA DIRECTOR
Deborah Hodges President & CEO Health Plans, Inc.
Westborough, MA
COMMITTEE CHAIRS
Captive Insurance Committee
Jeffrey Fitzgerald
Vice President
Innovative Captive Strategies
Waukee, IA
Future Leaders Committee
Erin Duffy
Director of Business Development
Imagine360
Wayne, PA
Price Transparency Committee
Christine Cooper CEO aequum, LLC
Cleveland, OH
Captive Insurance Advocacy Task Force
Jeffrey K. Simpson
Partner
Womble Bond Dickinson (US) LLP
Wilmington, DE
Workers’ Compensation Committee
Shelly Brotzge
Regional Underwriter, Group Self Insurance
Midwest Employers Casualty
Chesterfield, MO
SIEF BOARD OF DIRECTORS
CHAIRMAN
Nigel Wallbank
Preisdent
Leadenhall, LLC
Ocala, FL
PRESIDENT
Daniél C. Kimlinger, Ph.D.
CEO
MINES and Associates
Littleton, CO
DIRECTORS
Freda Bacon
Administrator
AL Self-Insured Workers' Comp Fund
Birmingham, AL
Les Boughner
Chairman
Advantage Insurance Management (USA) LLC
Charleston, SC
Alex Giordano
Chief Executive Officer
Hudson Atlantic Benefits
Bellmore, NY
Virginia Johnson
Strategic Account Director
Verisk/ISO Claims Partners
Charlotte, NC
* Also serves as Director
MAY 2023 65
SIIA NEW MEMBERS
REGULAR CORPORATE MEMBERS
Yves Zouzouambe
Founder/CEO
ASMLogic
Austin, TX
Joshua Axene
Partner & Consulting Actuary
Axene Health Partners, LLC
Murrieta, CA
Angela Sweeney, MHSA
Board Member
CDBAP, LLC
Covington, KY
Nick Soman CEO
Decent Mill Valley, CA
Jennifer Sines
Marketing Operations
Elixir North Canton, OH
Rey Colon CEO
Lyric McKinney, TX
Sarah Tarka Baer
Client Relations Director
PayneWest Insurance |
MMA Northwest
Missoula, MT
Derek Moore
Chief Revenue Officer
Radius Care
Sea Girt, NJ
Wayne Schellhammer President/CEO
Regenexx LL Des Moines, IA
Alan Gardner CEO
RxResults
Little Rock, AR
Matthew Robben
CTO
Serif Health
San Francisco, CA
Kevin Burns
Employee Benefit Consultant
The DeHayes Group
Fort Wayne, IN
SILVER MEMBERS
Warren Armstrong CEO
Global Health Management (Canada)
Victoria, BC
Ray Mals Group Sales Director
MedImpact
San Diego, CA
EMPLOYER MEMBER
Deborah Singleton
Director, Payroll & Benefits
National Association of
Chain Drug Stores
Arlington, VA
66 THE SELF-INSURER
MAY 2023

Connect with Zelis today at 888.311.3505 or visit zelis.com to get started.
Life Is Not Without Risk.
Catastrophic claims can arise unexpectedly. If the plan has the right Stop Loss protection in place, focus can remain on achieving business goals and welcoming Nadia back when it’s time. When you work with the experts at HM Insurance Group, you can have confidence that the claims will be paid. Find more on hmig.com

Nadia didn’t think her standard yearly check-up would lead to a cancer diagnosis. Neither did her self-funded employer. MTG-3456 (10/22) *Cost estimate based on HM Insurance Group historical Stop Loss data and additional industry observations, September 2022. In all states except New York, coverage may be underwritten by HM Life Insurance Company, Pittsburgh, PA, or Highmark Casualty Insurance Company, Pittsburgh, PA. In New York, coverage is underwritten by HM Life Insurance Company of New York, New York, NY. The coverage or service requested may not be available in all states and is subject to individual state approval. SECURE FINANCIAL PROTECTION WITH OUR INSURANCE AND REINSURANCE OPTIONS: Employer Stop Loss: Traditional Protection • Small Group Solutions • Coverage Over Reference-Based Pricing Managed Care Reinsurance: Provider Excess Loss • Health Plan Reinsurance
A discovery at a $200 annual exam could result in nearly $500,000 in cancer treatment protocol.*

By Bruce Shutan
By Bruce Shutan














































































































 Proud to be a Diamond Member
Proud to be a Diamond Member

